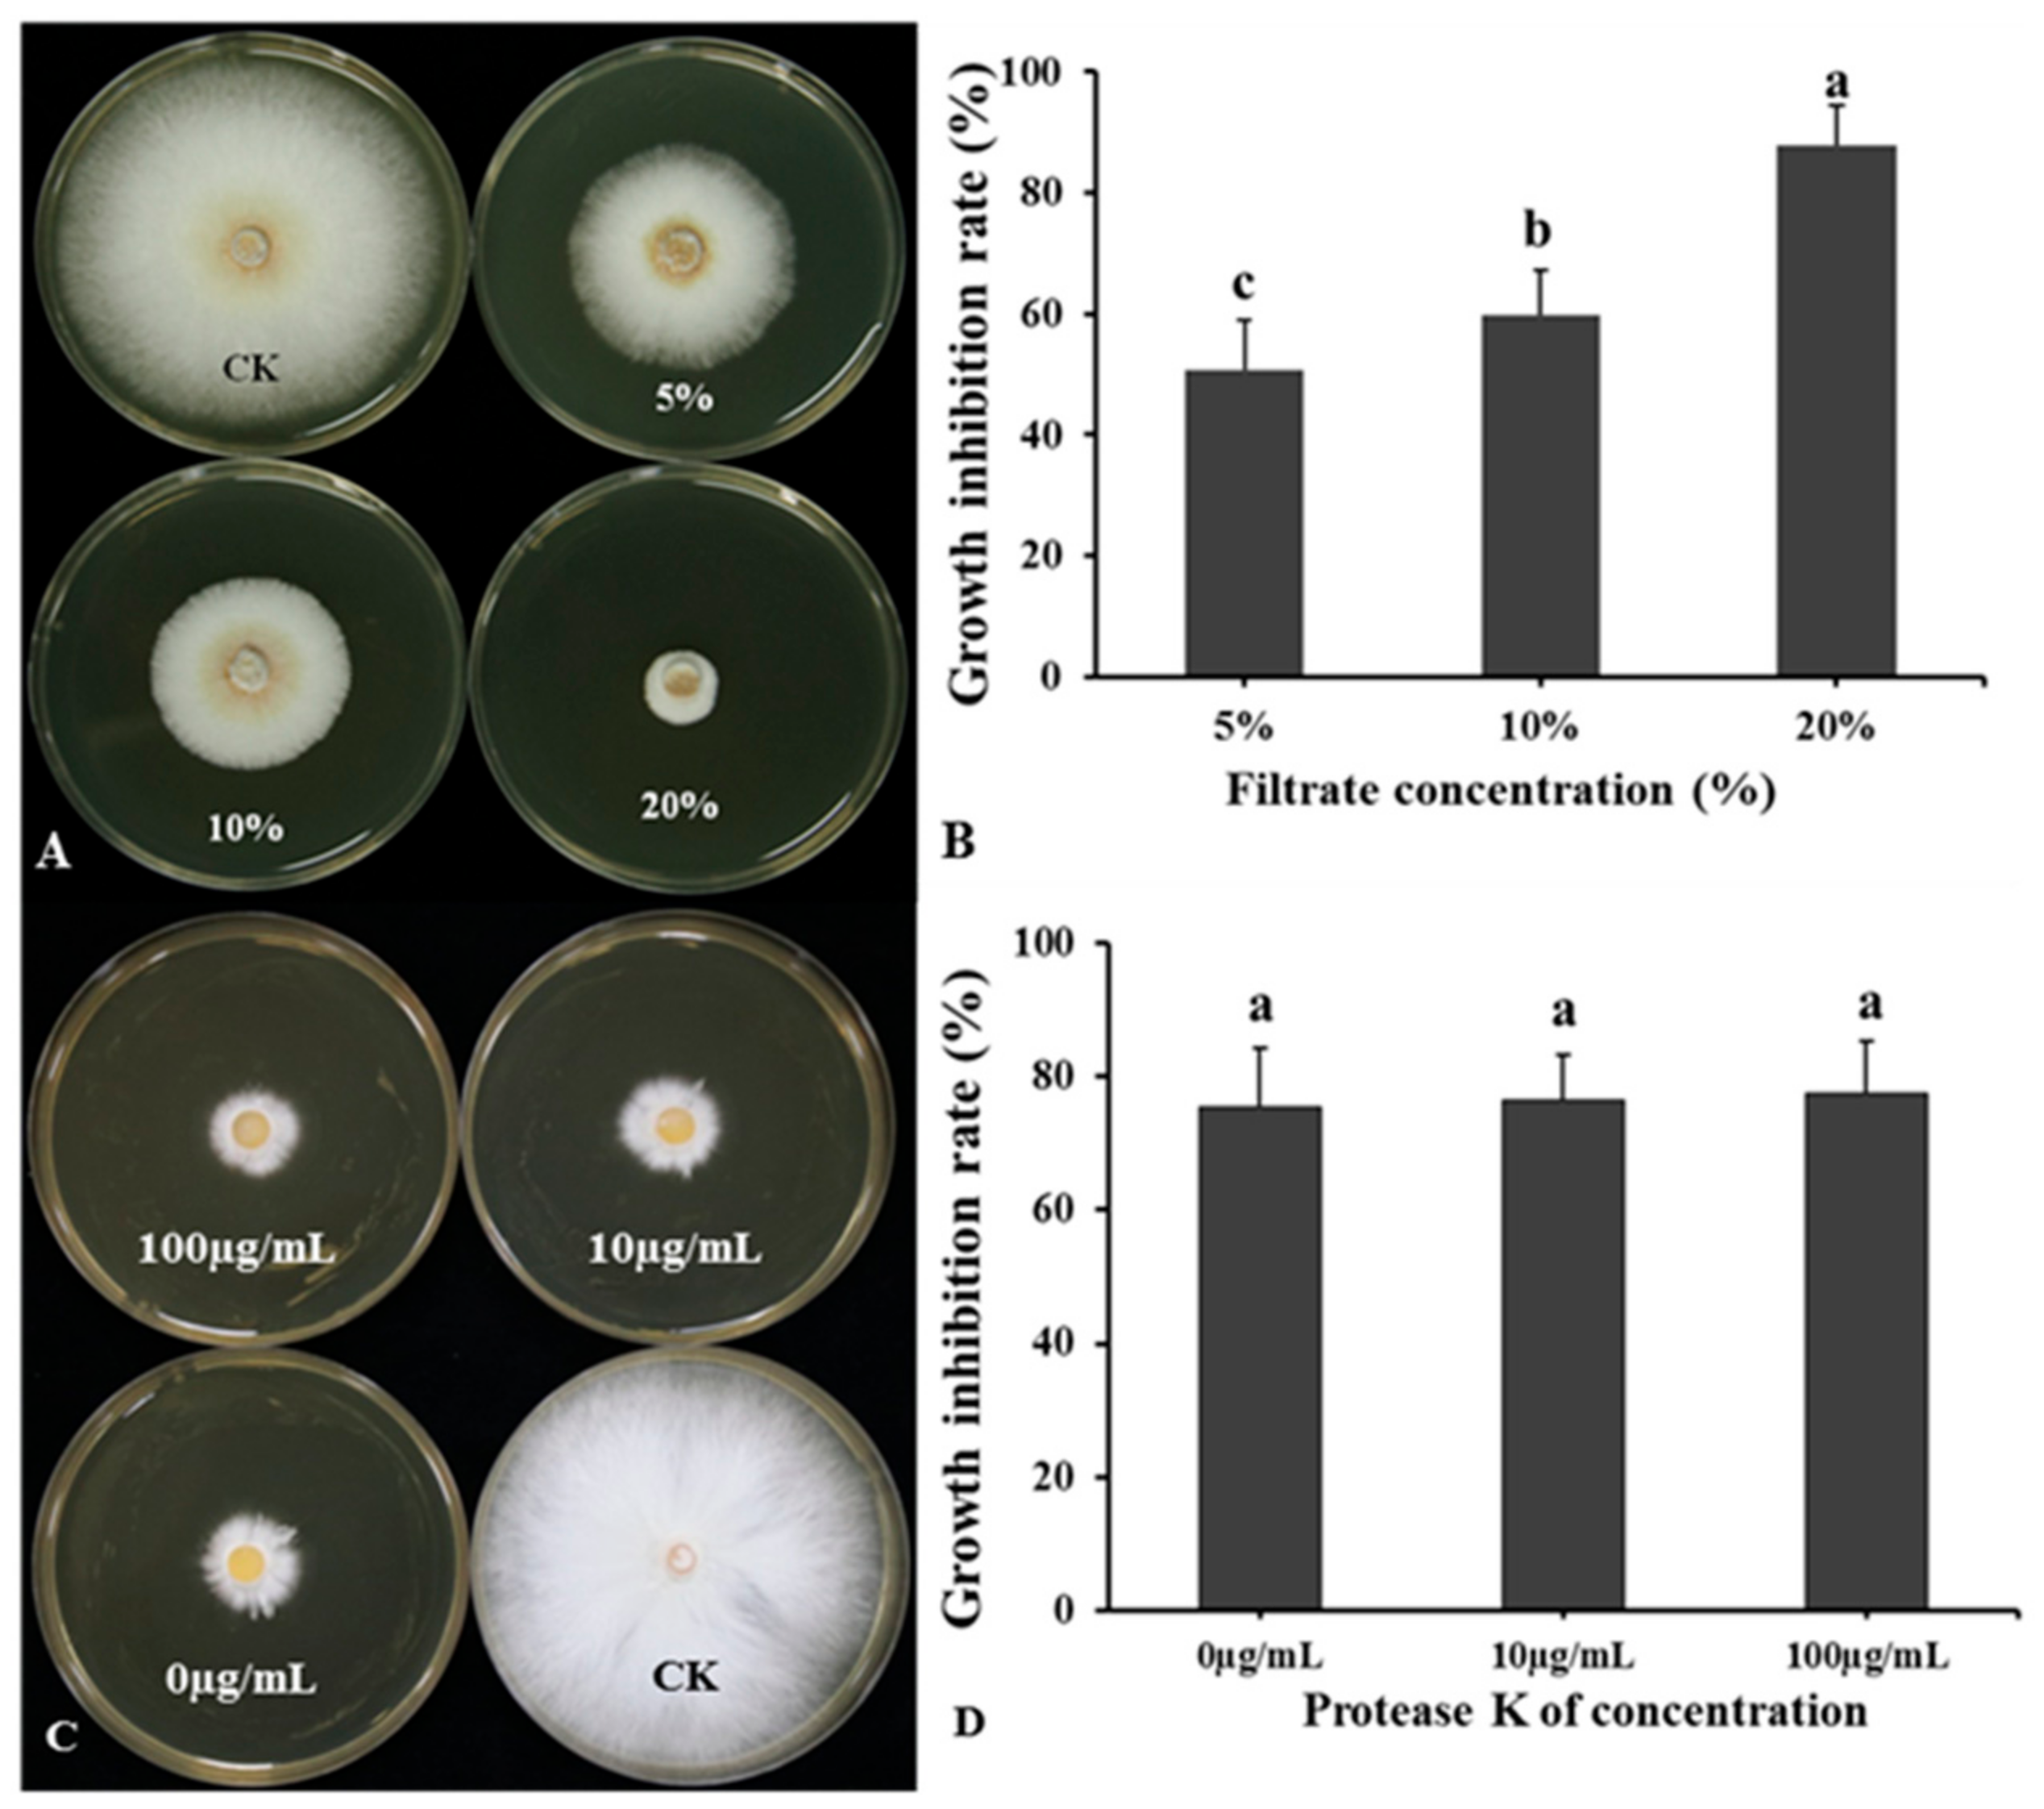
Jof 10 00849 g007
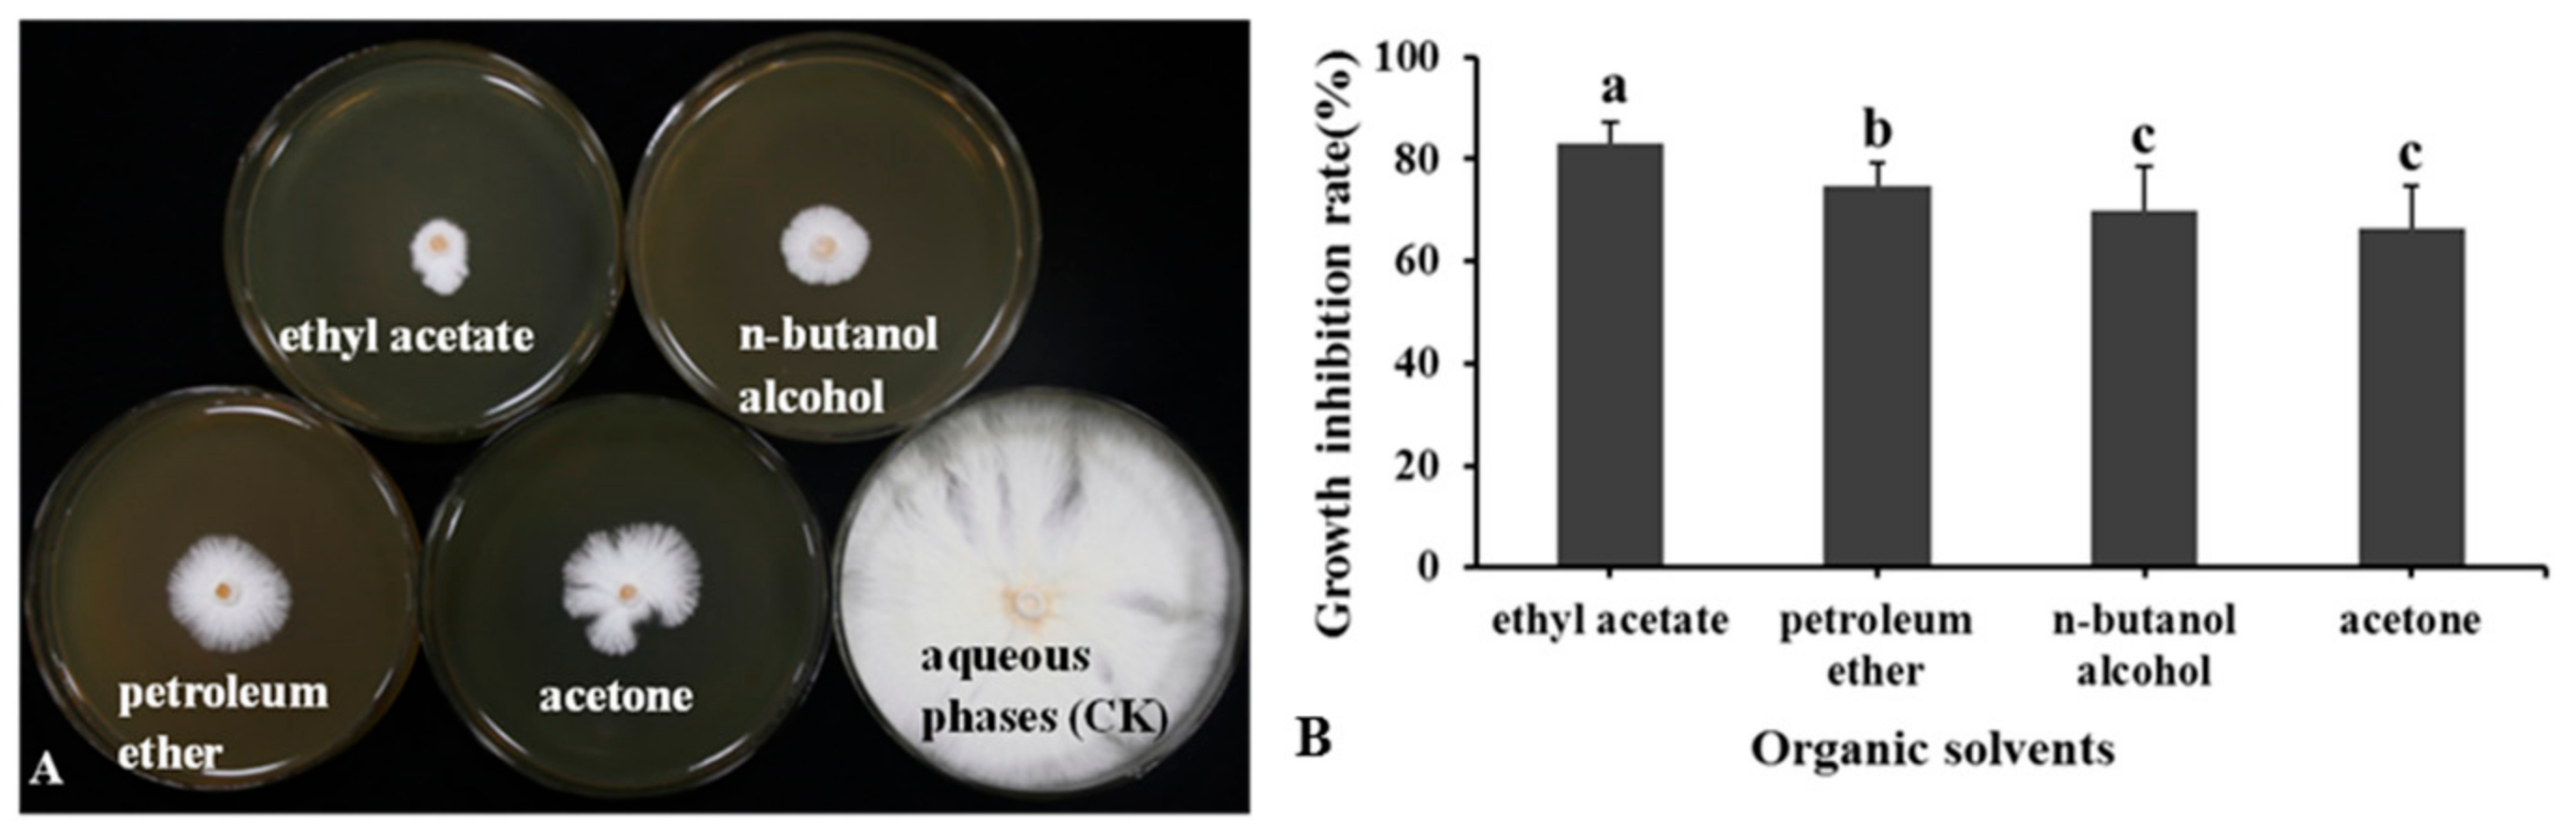
Jof 10 00849 g008

Biocontrol Potential of Endophytic Bacillus velezensis LSR7 Against Rubber Red Root Rot Disease
Abstract
1. Introduction
2. Materials and Methods
2.1. Endophytic Bacterium Isolation from Rubber Tree
2.2. Screening of Antagonistic Bacteria from Rubber Tree
2.3. Identification of LSR7
2.4. Effect of LSR7 on Rubber Red Root Rot Disease
2.5. Effect of LSR7 on Rubber Tree Seedling Growth
2.6. Analysis of the Characteristics of Endophytic Bacteria
2.6.1. Siderophore Production Determination
2.6.2. Detection of LSR7 Extracellular Enzymes
2.6.3. Detection of LSR7 Biofilm Formation
2.7. LSR7 Genomic Sequencing and Annotation
2.8. Antifungal Activity of LSR7 Secondary Metabolites
2.8.1. Effect of Temperature and Protease on Bacterial Culture Filtrate Antagonistic Activity
2.8.2. Detection of Antifungal Activity in Lipopeptide Metabolites of LSR7 Extracted by Different Solvents
2.9. Detection of Defense-Related Enzyme Activities in Plants
2.10. Statistical Analyses
3. Results
3.1. The Antagonistic Effect of LSR7 on G. Pseudoferreum and Its Identification
3.2. Inhibitory Effect of Strain LSR7 on Rubber Red Root Rot Disease in a Greenhouse
3.3. Effect of LSR7 on Rubber Seedling Growth
3.4. Determination of the Biological Characteristics of Strain LSR7
3.5. Genome Sequencing and Annotation of Strain LSR7
3.6. Effect of Temperature and Protease on BCF Antagonistic Activity
3.7. Detection of Antifungal Activity of LSR7 Lipopeptide Metabolites
3.8. Effects of LSR7 on the Activity of Rubber Defense-Related Enzymes
4. Discussion
5. Conclusions
Supplementary Materials
Author Contributions
Funding
Institutional Review Board Statement
Informed Consent Statement
Data Availability Statement
Conflicts of Interest
References
- Kohjiya, S.; Ikeda, Y. Chemistry, Manufacture and Applications of Natural Rubber; Woodhead Publishing: Sawston, UK, 2021. [Google Scholar]
- Men, X.; Wang, F.; Chen, G.-Q.; Zhang, H.-B.; Xian, M. Biosynthesis of natural rubber: Current state and perspectives. Int. J. Mol. Sci. 2018, 20, 50. [Google Scholar] [CrossRef] [PubMed]
- Puskas, J.E.; Cornish, K.; Kenzhe-Karim, B.; Mutalkhanov, M.; Kaszas, G.; Molnar, K. Natural rubber–Increasing diversity of an irreplaceable renewable resource. Heliyon 2024, 10, e25123. [Google Scholar] [CrossRef] [PubMed]
- Mahyudin, M.M.; Noran, A.S.; Ismail, M.Z.H.; Ahmad, K. Diseases of rubber trees: Malaysia as a case study. In Forest Microbiology; Elsevier: Amsterdam, The Netherlands, 2023; pp. 401–414. [Google Scholar]
- Mohammed, C.; Rimbawanto, A.; Page, D. Management of basidiomycete root-and stem-rot diseases in oil palm, rubber and tropical hardwood plantation crops. For. Pathol. 2014, 44, 428–446. [Google Scholar] [CrossRef]
- Nandris, D.; Nicole, M.; Geiger, J. Root rot diseases. Plant Dis. 1987, 71, 298–306. [Google Scholar] [CrossRef]
- Holliday, P. Robert Napper-pioneer of root disease control in Hevea rubber. Mycologist 1996, 10, 66–68. [Google Scholar] [CrossRef]
- Firmino, A.C.; Magalhães, I.P.; Gomes, M.E.; Fischer, I.H.; Junior, E.J.S.; Furtado, E.L. Monitoring Colletotrichum Colonization and Reproduction in Different Rubber Tree Clones. Plants 2022, 11, 905. [Google Scholar] [CrossRef]
- Kannojia, P.; Choudhary, K.K.; Srivastava, A.K.; Singh, A.K. PGPR bioelicitors: Induced systemic resistance (ISR) and proteomic perspective on biocontrol. In PGPR Amelioration in Sustainable Agriculture; Elsevier: Amsterdam, The Netherlands, 2019; pp. 67–84. [Google Scholar]
- Piotrowska-Seget, Z.; Engel, R.; Nowak, E.; Kozdrój, J. Successive soil treatment with captan or oxytetracycline affects non-target microorganisms. World J. Microbiol. Biotechnol. 2008, 24, 2843–2848. [Google Scholar] [CrossRef]
- Chu, L.; Lao, G.; Gao, X.; Liu, W.; Lu, Z.; Jin, P.; Miao, W. Bacillus velezensis HN-2 crude extract inhibits Erysiphe quercicola infection of rubber tree leaves. Physiol. Mol. Plant Pathol. 2022, 122, 101920. [Google Scholar] [CrossRef]
- Wang, M.; Zhang, Y.; Cai, H.; Zhao, X.; Zhu, Z.; Yan, Y.; Yin, K.; Cheng, G.; Li, Y.; Chen, G. A New Biocontrol Agent Bacillus velezensis SF334 against Rubber Tree Fungal Leaf Anthracnose and Its Genome Analysis of Versatile Plant Probiotic Traits. J. Fungi 2024, 10, 158. [Google Scholar] [CrossRef]
- Shabbir, I.; Abd Samad, M.Y.; Othman, R.; Wong, M.-Y.; Sulaiman, Z.; Jaafar, N.M.; Bukhari, S.A.H. White root rot disease suppression in rubber plant with microbial co-inoculants and silicon addition. Rhizosphere 2020, 15, 100221. [Google Scholar] [CrossRef]
- Santoyo, G.; Moreno-Hagelsieb, G.; del Carmen Orozco-Mosqueda, M.; Glick, B.R. Plant growth-promoting bacterial endophytes. Microbiol. Res. 2016, 183, 92–99. [Google Scholar] [CrossRef] [PubMed]
- Ali, M.A.; Ahmed, T.; Ibrahim, E.; Rizwan, M.; Chong, K.P.; Yong, J.W.H. A review on mechanisms and prospects of endophytic bacteria in biocontrol of plant pathogenic fungi and their plant growth-promoting activities. Heliyon 2024, 10, e31573. [Google Scholar] [CrossRef]
- Comby, M.; Gacoin, M.; Robineau, M.; Rabenoelina, F.; Ptas, S.; Dupont, J.; Profizi, C.; Baillieul, F. Screening of wheat endophytes as biological control agents against Fusarium head blight using two different in vitro tests. Microbiol. Res. 2017, 202, 11–20. [Google Scholar] [CrossRef] [PubMed]
- Hallmann, J.; Quadt-Hallmann, A.; Mahaffee, W.; Kloepper, J. Bacterial endophytes in agricultural crops. Can. J. Microbiol. 1997, 43, 895–914. [Google Scholar] [CrossRef]
- Jian, W.; Chen, Y.; Liu, S.; Ou, X.; Sun, L.; Gong, H.; Mu, Q.; Li, Z.; Zhao, Z. Biocontrol efficacy and mechanism of endophytic Bacillus velezensis HE-23 from Aucklandia lappa roots against the gray mold of postharvest tomato. Postharvest Biol. Technol. 2024, 217, 113104. [Google Scholar] [CrossRef]
- Morales-Cedeño, L.R.; del Carmen Orozco-Mosqueda, M.; Loeza-Lara, P.D.; Parra-Cota, F.I.; de Los Santos-Villalobos, S.; Santoyo, G. Plant growth-promoting bacterial endophytes as biocontrol agents of pre-and post-harvest diseases: Fundamentals, methods of application and future perspectives. Microbiol. Res. 2021, 242, 126612. [Google Scholar] [CrossRef] [PubMed]
- Sriwati, R.; Maulidia, V.; Intan, N.; Oktarina, H.; Khairan, K.; Skala, L.; Mahmud, T. Endophytic bacteria as biological agents to control fusarium wilt disease and promote tomato plant growth. Physiol. Mol. Plant Pathol. 2023, 125, 101994. [Google Scholar] [CrossRef]
- Zhang, Y.-J.; Cao, X.-Y.; Chen, Y.-J.; Cong, H.; Wang, Y.-M.; Jiang, J.-H.; Li, L.-D. Potential utility of endophytic Bacillus altitudinis strain P32-3 as a biocontrol agent for the postharvest prevention of sweet potato black rot. Biol. Control 2023, 186, 105350. [Google Scholar] [CrossRef]
- Shreshtha, K.; Raj, S.; Pal, A.K.; Tripathi, P.; Choudhary, K.K.; Mitra, D.; Rani, A.; de los Santos-Villalobos, S.; Tripathi, V. Isolation and Identification of Rhizospheric and Endophytic Bacteria from Cucumber Plants Irrigated with Wastewater: Exploring Their Roles in Plant Growth Promotion and Disease Suppression. Curr. Res. Microb. Sci. 2024, 7, 100256. [Google Scholar] [CrossRef]
- Velmurugan, S.; Ashajyothi, M.; Charishma, K.; Kumar, S.; Balamurugan, A.; Javed, M.; Karwa, S.; Prakash, G.; Subramanian, S.; Gogoi, R. Enhancing defense against rice blast disease: Unveiling the role of leaf endophytic firmicutes in antifungal antibiosis and induced systemic resistance. Microb. Pathog. 2023, 184, 106326. [Google Scholar] [CrossRef]
- Carmen, O.M.d.; Ajay, K.; Emmanuel, F.A.; Oluranti, B.O.; Gerardo, P.; Gustavo, S. Agroecological Management of the Grey Mould Fungus Botrytis cinerea by Plant Growth-Promoting Bacteria. Plants 2023, 12, 637. [Google Scholar] [CrossRef] [PubMed]
- Sirikamonsathien, T.; Kenji, M.; Dethoup, T. Potential of endophytic Trichoderma in controlling Phytophthora leaf fall disease in rubber (Hevea brasiliensis). Biol. Control 2023, 179, 105175. [Google Scholar] [CrossRef]
- Zheng, T.-w.; Liu, L.; Nie, Q.-w.; Hsiang, T.; Sun, Z.-x.; Zhou, Y. Isolation, identification and biocontrol mechanisms of endophytic bacterium D61-A from Fraxinus hupehensis against Rhizoctonia solani. Biol. Control 2021, 158, 104621. [Google Scholar] [CrossRef]
- Chen, L.; Shi, H.; Heng, J.; Wang, D.; Bian, K. Antimicrobial, plant growth-promoting and genomic properties of the peanut endophyte Bacillus velezensis LDO2. Microbiol. Res. 2019, 218, 41–48. [Google Scholar] [CrossRef]
- Relman, D. Universal bacterial 16S rDNA amplification and sequencing. In Diagnostic Molecular Microbiology: Principles and Applications; ASM Press: Washington, DC, USA, 1993; pp. 489–495. [Google Scholar]
- Yamamoto, S.; Harayama, S. PCR Amplification and Direct Sequencing of gyrB Genes with Universal Primers and Their Application to the Detection and Taxonomic Analysis of Pseudomonas putida Strains. Appl. Environ. Microbiol. 1995, 61, 1104–1109. [Google Scholar] [CrossRef] [PubMed]
- Livak, K.J.; Schmittgen, T.D. Analysis of relative gene expression data using real-time quantitative PCR and the 2−ΔΔCT method. Methods 2001, 25, 402–408. [Google Scholar] [CrossRef]
- Shin, S.H.; Lim, Y.; Lee, S.E.; Yang, N.W.; Rhee, J.H. CAS agar diffusion assay for the measurement of siderophores in biological fluids. J. Microbiol. Methods 2001, 44, 89–95. [Google Scholar] [CrossRef]
- Jangir, M.; Pathak, R.; Sharma, S.; Sharma, S. Biocontrol mechanisms of Bacillus sp., isolated from tomato rhizosphere, against Fusarium oxysporum f. sp. lycopersici. Biol. Control 2018, 123, 60–70. [Google Scholar] [CrossRef]
- Zheng, Y.; Xue, Q.-Y.; Xu, L.-L.; Xu, Q.; Lu, S.; Gu, C.; Guo, J.-H. A screening strategy of fungal biocontrol agents towards Verticillium wilt of cotton. Biol. Control 2011, 56, 209–216. [Google Scholar] [CrossRef]
- Guo, X.; Chen, D.-D.; Peng, K.-S.; Cui, Z.-W.; Zhang, X.-J.; Li, S.; Zhang, Y.-A. Identification and characterization of Bacillus subtilis from grass carp (Ctenopharynodon idellus) for use as probiotic additives in aquatic feed. Fish Shellfish Immunol. 2016, 52, 74–84. [Google Scholar] [CrossRef]
- Slama, H.B.; Cherif-Silini, H.; Chenari Bouket, A.; Qader, M.; Silini, A.; Yahiaoui, B.; Alenezi, F.N.; Luptakova, L.; Triki, M.A.; Vallat, A.; et al. Screening for Fusarium Antagonistic Bacteria From Contrasting Niches Designated the Endophyte Bacillus halotolerans as Plant Warden Against Fusarium. Front. Microbiol. 2018, 9, 3236. [Google Scholar] [CrossRef] [PubMed]
- Wang, L.; Li, X.; Medison, R.G.; Zheng, T.; Meng, X.; Sun, Z.; Zhou, Y. Biocontrol efficacy of Burkholderia pyrrocinia S17-377 in controlling rice sheath blight. Biol. Control 2023, 187, 105368. [Google Scholar] [CrossRef]
- Wick, R.R.; Judd, L.M.; Gorrie, C.L.; Holt, K.E. Unicycler: Resolving bacterial genome assemblies from short and long sequencing reads. PLoS Comput. Biol. 2017, 13, e1005595. [Google Scholar] [CrossRef] [PubMed]
- Torsten, S. Prokka: Rapid prokaryotic genome annotation. Bioinformatics 2014, 30, 2068–2069. [Google Scholar]
- Zuguang, G.; Lei, G.; Roland, E.; Matthias, S.; Benedikt, B. circlize Implements and enhances circular visualization in R. Bioinformatics 2014, 30, 2811–2812. [Google Scholar]
- Meng, X.; Luo, Y.; Zhao, X.; Fu, Y.; Zou, L.; Cai, H.; Zhou, Y.; Tu, M. Isolation, Identification, and Biocontrol Mechanisms of Endophytic Burkholderia arboris DHR18 from Rubber Tree against Red Root Rot Disease. Microorganisms 2024, 12, 1793. [Google Scholar] [CrossRef]
- Tu, M.; Zhu, Z.; Zhao, X.; Cai, H.; Zhang, Y.; Yan, Y.; Yin, K.; Sha, Z.; Zhou, Y.; Chen, G.; et al. The versatile plant probiotic bacterium Bacillus velezensis SF305 reduces red root rot disease severity in the rubber tree by degrading the mycelia of Ganoderma pseudoferreum. J. Integr. Agri. 2024. [Google Scholar] [CrossRef]
- Myo, E.M.; Liu, B.; Ma, J.; Shi, L.; Jiang, M.; Zhang, K.; Ge, B. Evaluation of Bacillus velezensis NKG-2 for bio-control activities against fungal diseases and potential plant growth promotion. Biol. Control 2019, 134, 23–31. [Google Scholar] [CrossRef]
- Ruiz-Herrera, J.; Victoria Elorza, M.; Valentín, E.; Sentandreu, R. Molecular organization of the cell wall of Candida albicans and its relation to pathogenicity. FEMS Yeast Res. 2006, 6, 14–29. [Google Scholar] [CrossRef]
- Hui, L.; Ying, G.; Yilun, D.; Lu, Z.; Songhao, R.; Wenqian, C.; Miaomiao, L.; Hong, X.; Xiaoling, G.; Rongjun, C.; et al. Isolation and evaluation of endophytic Bacillus tequilensis GYLH001 with potential application for biological control of Magnaporthe oryzae. PLoS ONE 2018, 13, e0203505. [Google Scholar]
- Beneduzi, A.; Ambrosini, A.; Passaglia, L.M. Plant growth-promoting rhizobacteria (PGPR): Their potential as antagonists and biocontrol agents. Genet. Mol. Biol. 2012, 35, 1044–1051. [Google Scholar] [CrossRef] [PubMed]
- Lopes, R.; Tsui, S.; Gonçalves, P.J.; de Queiroz, M.V. A look into a multifunctional toolbox: Endophytic Bacillus species provide broad and underexploited benefits for plants. World J. Microbiol. Biotechnol. 2018, 34, 94. [Google Scholar] [CrossRef]
- Liu, L.; Medison, R.G.; Zheng, T.-W.; Meng, X.-J.; Sun, Z.-X.; Zhou, Y. Biocontrol potential of Bacillus amyloliquefaciens YZU-SG146 from Fraxinus hupehensis against Verticillium wilt of cotton. Biol. Control 2023, 183, 105246. [Google Scholar] [CrossRef]
- Skariyachan, S.; Sridhar, V.S.; Packirisamy, S.; Kumargowda, S.T.; Challapilli, S.B. Recent perspectives on the molecular basis of biofilm formation by Pseudomonas aeruginosa and approaches for treatment and biofilm dispersal. Folia Microbiol. 2018, 63, 413–432. [Google Scholar] [CrossRef]
- Sun, D.; Zhuo, T.; Hu, X.; Fan, X.; Zou, H. Identification of a Pseudomonas putida as biocontrol agent for tomato bacterial wilt disease. Biol. Control 2017, 114, 45–50. [Google Scholar] [CrossRef]
- Yang, Y.; Chen, R.; Rahman, M.U.; Wei, C.; Fan, B. The sprT Gene of Bacillus velezensis FZB42 Is Involved in Biofilm Formation and Bacilysin Production. Int. J. Mol. Sci. 2023, 24, 16815. [Google Scholar] [CrossRef] [PubMed]
- Ruihuan, Y.; Qing, S.; Tingting, H.; Yichao, Y.; Shengzhang, L.; Yuan, F.; Ying, L.; Linlin, L.; Longyu, L.; Xiaozheng, W.; et al. The natural pyrazolotriazine pseudoiodinine from Pseudomonas mosselii 923 inhibits plant bacterial and fungal pathogens. Nat. Commun. 2023, 14, 734. [Google Scholar]
- Rabbee, M.F.; Ali, M.S.; Choi, J.; Hwang, B.S.; Jeong, S.C.; Baek, K.-H. Bacillus velezensis: A valuable member of bioactive molecules within plant microbiomes. Molecules 2019, 24, 1046. [Google Scholar] [CrossRef]
- Kim, S.; Kim, H.M.; Yang, J.E.; Jeong, S.-G.; Kim, Y.Y.; Hwang, I.M.; Yu, N.H.; Kim, J.-C.; Park, H.W. Biological control of the shot-hole disease in flowering cherry tree using antimicrobial compounds produced by Bacillus velezensis 8–2. Chem. Biol. Technol. Agric. 2024, 11, 87. [Google Scholar] [CrossRef]
- Ashajyothi, M.; Mahadevakumar, S.; Venkatesh, Y.; Sarma, P.V.; Danteswari, C.; Balamurugan, A.; Prakash, G.; Khandelwal, V.; Tarasatyavathi, C.; Podile, A.R. Correction: Comprehensive genomic analysis of Bacillus subtilis and Bacillus paralicheniformis associated with the pearl millet panicle reveals their antimicrobial potential against important plant pathogens. BMC Plant Biol. 2024, 24, 264. [Google Scholar] [CrossRef]
- Wu, L.; Wu, H.; Chen, L.; Yu, X.; Borriss, R.; Gao, X. Difficidin and bacilysin from Bacillus amyloliquefaciens FZB42 have antibacterial activity against Xanthomonas oryzae rice pathogens. Sci. Rep. 2015, 5, 12975. [Google Scholar] [CrossRef] [PubMed]
- Pandey, C.; Prabha, D.; Negi, Y.K.; Maheshwari, D.K.; Dheeman, S.; Gupta, M. Macrolactin A mediated biocontrol of Fusarium oxysporum and Rhizoctonia solani infestation on Amaranthus hypochondriacus by Bacillus subtilis BS-58. Front. Microbiol. 2023, 14, 1105849. [Google Scholar] [CrossRef] [PubMed]
- Kashyap, A.S.; Manzar, N.; Rajawat, M.V.S.; Kesharwani, A.K.; Singh, R.P.; Dubey, S.; Pattanayak, D.; Dhar, S.; Lal, S.; Singh, D. Screening and biocontrol potential of rhizobacteria native to gangetic plains and hilly regions to induce systemic resistance and promote plant growth in chilli against bacterial wilt disease. Plants 2021, 10, 2125. [Google Scholar] [CrossRef] [PubMed]
- Richter, H.; Lieberei, R.; Strnad, M.; Novák, O.; Gruz, J.; Rensing, S.A.; von Schwartzenberg, K. Polyphenol oxidases in Physcomitrella: Functional PPO1 knockout modulates cytokinin-dependent developmentin the moss Physcomitrella patens. J. Exp. Bot. 2012, 63, 5121–5135. [Google Scholar] [CrossRef]
- Shine, M.; Yang, J.W.; El-Habbak, M.; Nagyabhyru, P.; Fu, D.Q.; Navarre, D.; Ghabrial, S.; Kachroo, P.; Kachroo, A. Cooperative functioning between phenylalanine ammonia lyase and isochorismate synthase activities contributes to salicylic acid biosynthesis in soybean. New Phytol. 2016, 212, 627–636. [Google Scholar] [CrossRef]
- Wei, Z.-M.; Laby, R.J.; Zumoff, C.H.; Bauer, D.W.; He, S.Y.; Collmer, A.; Beer, S.V. Harpin, elicitor of the hypersensitive response produced by the plant pathogen Erwinia amylovora. Science 1992, 257, 85–88. [Google Scholar] [CrossRef]
- Sahu, P.K.; Singh, S.; Gupta, A.; Singh, U.B.; Brahmaprakash, G.P.; Saxena, A.K. Antagonistic potential of bacterial endophytes and induction of systemic resistance against collar rot pathogen Sclerotium rolfsii in tomato. Biol. Control 2019, 137, 104014. [Google Scholar] [CrossRef]
- Sahu, P.K.; Singh, S.; Gupta, A.R.; Gupta, A.; Singh, U.B.; Manzar, N.; Bhowmik, A.; Singh, H.V.; Saxena, A.K. Endophytic bacilli from medicinal-aromatic perennial Holy basil (Ocimum tenuiflorum L.) modulate plant growth promotion and induced systemic resistance against Rhizoctonia solani in rice (Oryza sativa L.). Biol. Control 2020, 150, 104353. [Google Scholar] [CrossRef]
- Meng, X.-J.; Wang, L.-Q.; Ma, B.-G.; Wei, X.-H.; Zhou, Y.; Sun, Z.-X.; Li, Y.-Y. Screening, identification and evaluation of an acidophilic strain of Bacillus velezensis B4-7 for the biocontrol of tobacco bacterial wilt. Front. Plant Sci. 2024, 15, 1360173. [Google Scholar] [CrossRef]

| Strain | Antifungal Bandwidth (mm) | Inhibition Rate (%) |
|---|---|---|
| WSR6 | 10.54 ± 0.52 | 72.32 ± 1.11 b |
| LSR7 | 13.86 ± 0.45 | 81.06 ± 2.68 a |
| DHS35 | 7.67 ± 0.55 | 66.67 ± 1.33 c |
| DHR46 | 8.99 ± 0.72 | 69.85 ± 1.74 c |
| DHR27 | 12.92 ± 0.32 | 79.33 ± 0.78 a |
| BHS5 | 10.85 ± 0.33 | 74.33 ± 0.80 b |
| QSS3 | 8.62 ± 0.62 | 68.96 ± 1.49 c |
| QHL1 | 12.94 ± 0.45 | 79.38 ± 1.08 a |
Disclaimer/Publisher’s Note: The statements, opinions and data contained in all publications are solely those of the individual author(s) and contributor(s) and not of MDPI and/or the editor(s). MDPI and/or the editor(s) disclaim responsibility for any injury to people or property resulting from any ideas, methods, instructions or products referred to in the content. |
© 2024 by the authors. Licensee MDPI, Basel, Switzerland. This article is an open access article distributed under the terms and conditions of the Creative Commons Attribution (CC BY) license (https://creativecommons.org/licenses/by/4.0/).
Share and Cite
Meng, X.; Cai, H.; Luo, Y.; Zhao, X.; Fu, Y.; Zou, L.; Zhou, Y.; Tu, M. Biocontrol Potential of Endophytic Bacillus velezensis LSR7 Against Rubber Red Root Rot Disease. J. Fungi 2024, 10, 849. https://doi.org/10.3390/jof10120849
Meng X, Cai H, Luo Y, Zhao X, Fu Y, Zou L, Zhou Y, Tu M. Biocontrol Potential of Endophytic Bacillus velezensis LSR7 Against Rubber Red Root Rot Disease. Journal of Fungi. 2024; 10(12):849. https://doi.org/10.3390/jof10120849
Chicago/Turabian StyleMeng, Xiangjia, Haibin Cai, Youhong Luo, Xinyang Zhao, Yongwei Fu, Lifang Zou, Yi Zhou, and Min Tu. 2024. "Biocontrol Potential of Endophytic Bacillus velezensis LSR7 Against Rubber Red Root Rot Disease" Journal of Fungi 10, no. 12: 849. https://doi.org/10.3390/jof10120849
APA StyleMeng, X., Cai, H., Luo, Y., Zhao, X., Fu, Y., Zou, L., Zhou, Y., & Tu, M. (2024). Biocontrol Potential of Endophytic Bacillus velezensis LSR7 Against Rubber Red Root Rot Disease. Journal of Fungi, 10(12), 849. https://doi.org/10.3390/jof10120849

